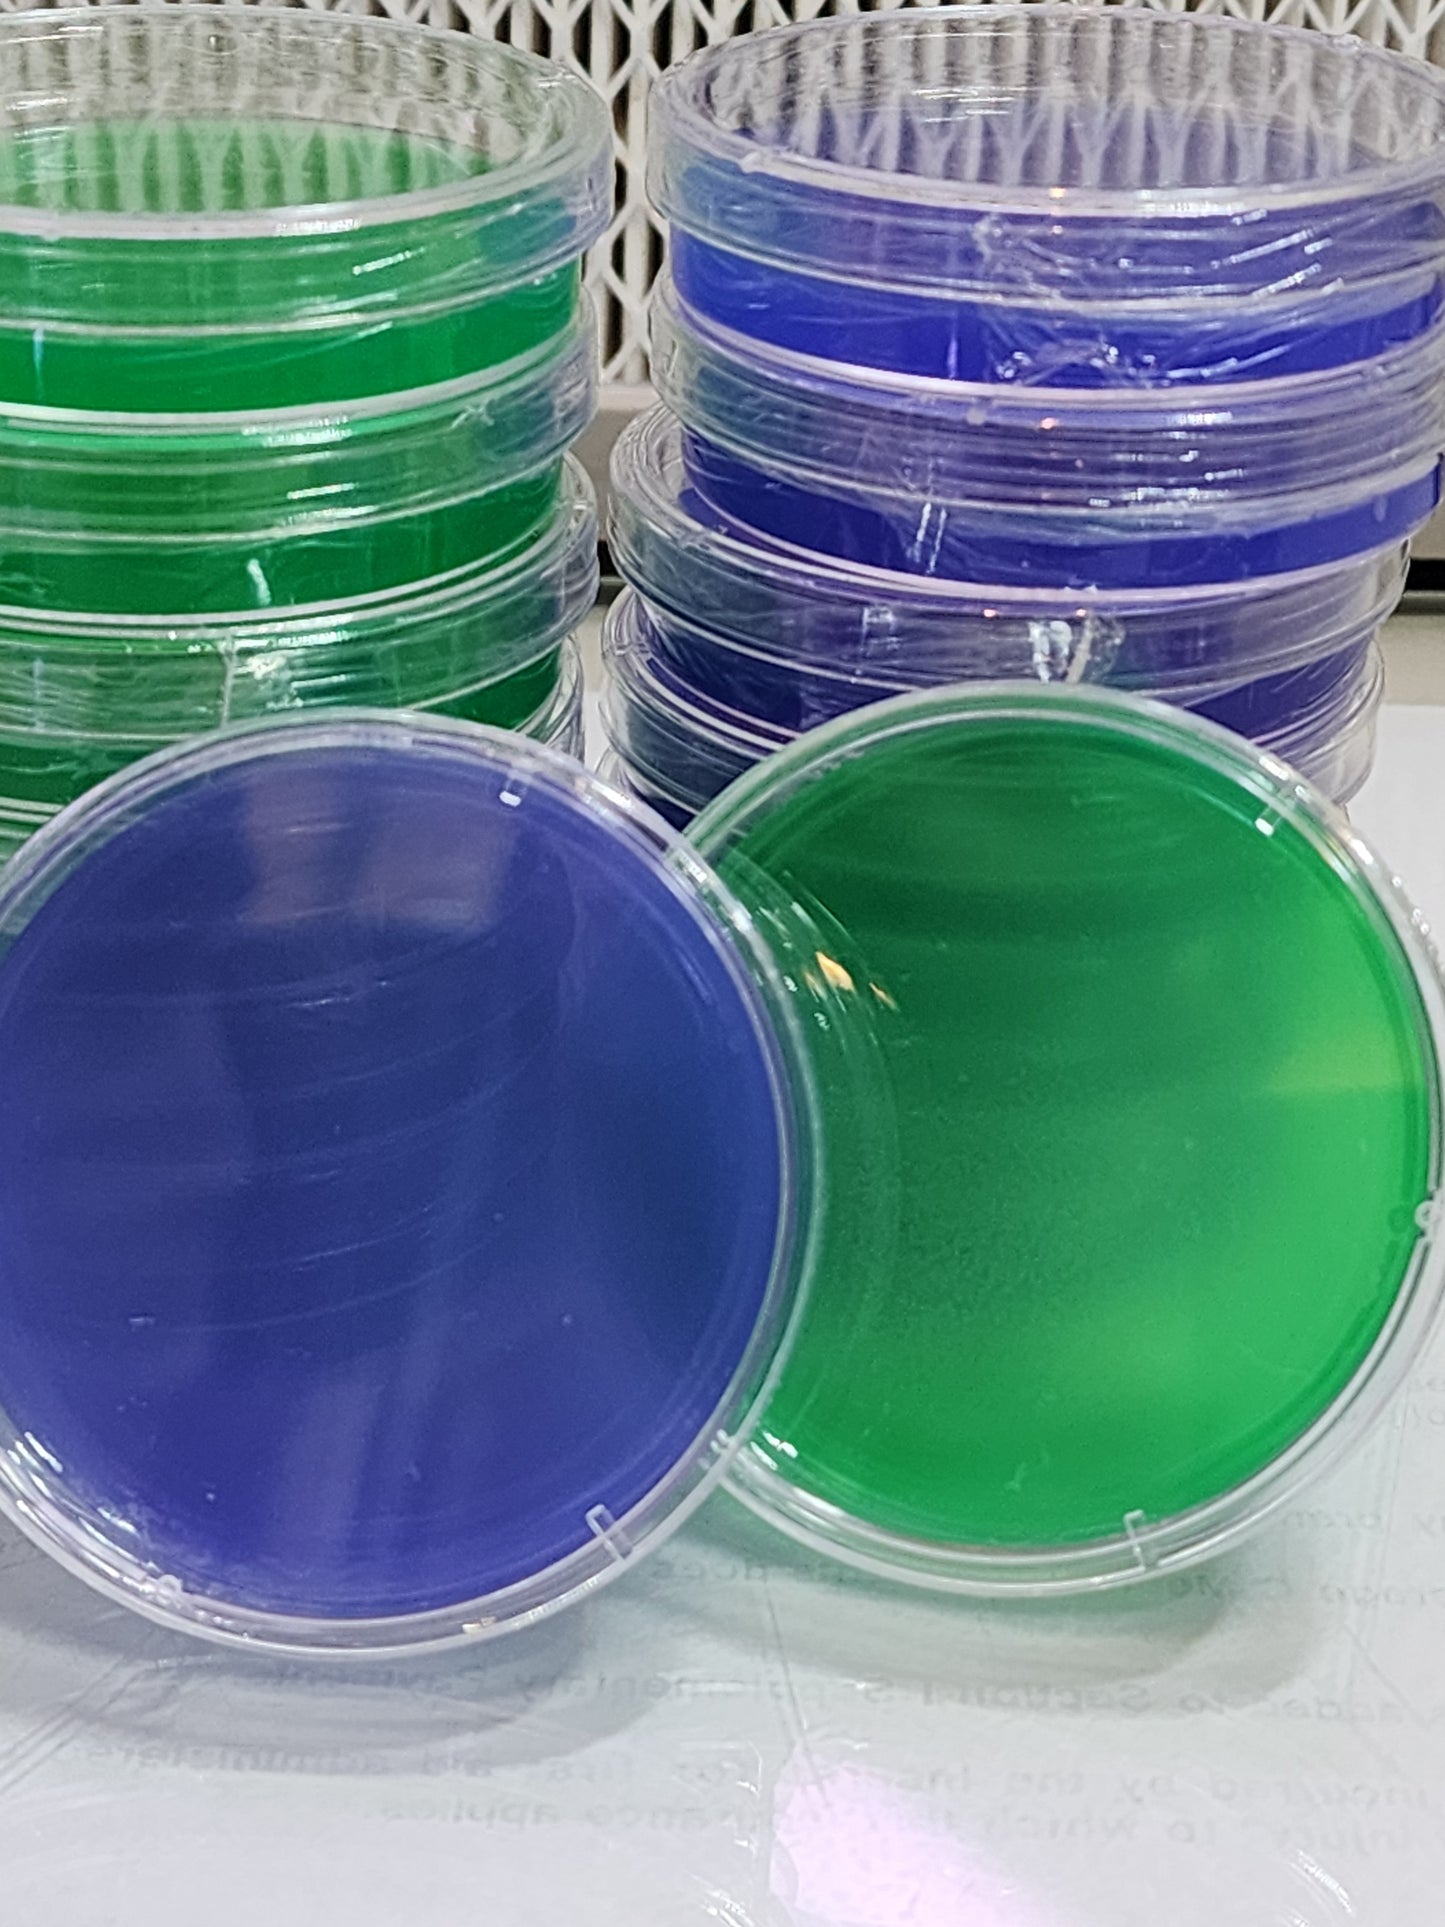
Grain Water Agar Dish / Plate

Grain Water Agar Dish / Plate
Grain Water Agar Dish / Plate
Regular price
$2.50
Regular price
Sale price
$2.50
Shipping calculated at checkout.
Quantity
Couldn't load pickup availability
60mm Sterile Ready-to-Use Agar Petri Dishes
Grain Water Agar plates are made with Agar Agar, Grain Water, Gypsum
All plates are poured in front of a 2’x4′ Laminar flow hood